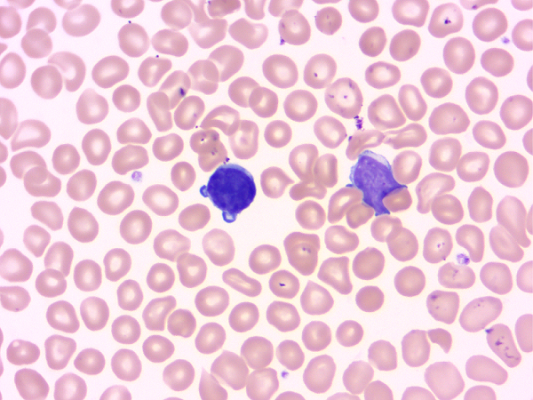
圖片1.png

寵物貓給很多家庭帶來了歡樂,但是“養(yǎng)貓對孕婦和胎兒的健康不好”這個(gè)說法一直困擾著愛貓人士。養(yǎng)貓對孕婦的所有影響中,人們最擔(dān)心的就是弓形蟲感染。一邊是對腹中寶寶健康的擔(dān)憂,一邊是不能舍棄陪伴多年有著深厚感情的貓咪。養(yǎng)貓與懷孕真的不能兩全嗎?
● 弓形蟲是什么?
弓形蟲很小,肉眼看不到,寄生于人和動物的細(xì)胞內(nèi),隨血液流動,到達(dá)全身各部位。弓形蟲有滋養(yǎng)體、包囊、裂殖體、配子體和卵囊5種不同形態(tài),其中滋養(yǎng)體和包囊可存在于人體內(nèi),其余形態(tài)只能存在終宿主——貓和貓科動物身上。貓主要通過受感染的貓糞,以及捕食老鼠和鳥獲得弓形蟲感染。一般來講,貓第一次感染弓形蟲后會在感染的最初兩周排出卵囊,卵囊在外界發(fā)育1~2天或更長時(shí)間才具有傳染性。
弓形蟲寄生于人和動物的細(xì)胞內(nèi)
● 弓形蟲對孕婦有什么危害?
免疫功能正常的成年人感染弓形蟲多以隱性感染為主,只有10%~20%的患者有輕微感冒樣癥狀。免疫力低下時(shí),感染可引起發(fā)熱、疲倦、淋巴結(jié)和肝脾大等。若女性在懷孕初期感染弓形蟲,弓形蟲可通過胎盤屏障,使胎兒發(fā)生弓形蟲感染,從而導(dǎo)致流產(chǎn)、早產(chǎn)、死產(chǎn),或者無腦兒、腦積水、小頭畸形、小眼畸形、智力發(fā)育不全等畸形。
● 家有孕婦如何預(yù)防弓形蟲感染呢?
1. 注意飲食衛(wèi)生
并非只有貓才能傳播弓形蟲,被污染的食物和環(huán)境都有可能。弓形蟲主要經(jīng)口傳播,因此除了貓,未洗凈的蔬菜水果、生的或半生的肉,以及被生肉污染的熟食都可能傳播。因此,養(yǎng)成飯前、便后勤洗手的好習(xí)慣,能最大程度減少“病從口入”的機(jī)會。
2. 科學(xué)養(yǎng)貓
貓進(jìn)食了受感染的老鼠或鳥類可能會感染弓形蟲。因此,貓要養(yǎng)在家里,喂熟食或成品貓糧,不讓它們外出捕食。同時(shí)要注意日常生活衛(wèi)生,貓排便后及時(shí)或24小時(shí)內(nèi)清理,避免弓形蟲的卵囊發(fā)育。懷孕最初3個(gè)月內(nèi),孕婦應(yīng)嚴(yán)格與寵物保持距離,特別要避免接觸貓的糞便,如果接觸,接觸后一定要認(rèn)真洗手。

孕婦要避免接觸貓的糞便
3. 積極進(jìn)行弓形蟲檢測
主人受孕前可以帶貓做一次動物弓形蟲檢測。如果弓形蟲抗體陽性,表明貓已感染弓形蟲或有某種程度的免疫力;若弓形蟲抗體為陰性,貓可能未被感染,但也要注意預(yù)防。
同時(shí)女性在備孕期間和懷孕早期可到醫(yī)院做弓形蟲常規(guī)檢查,以減少胎兒先天性弓形蟲病的發(fā)生。弓形蟲IgM和IgG抗體如果均為陰性,表示孕婦沒有感染過弓形蟲,此時(shí)須做好感染的預(yù)防,并定期復(fù)查。如果IgG抗體陽性,提示既往發(fā)生過感染;但如果IgM抗體為陽性,就提示近期感染了弓形蟲。
總之,雖然弓形蟲可能會導(dǎo)致孕婦流產(chǎn)或胎兒畸形,但是我國弓形蟲的發(fā)病率并不高,孕婦只要正確認(rèn)識弓形蟲,做到科學(xué)養(yǎng)貓、有效預(yù)防,是可以在懷孕期間養(yǎng)貓的。

作者:侯佳宜 山西省中醫(yī)院 副主任技師
審核:李新玲 山西省中醫(yī)院 主任醫(yī)師